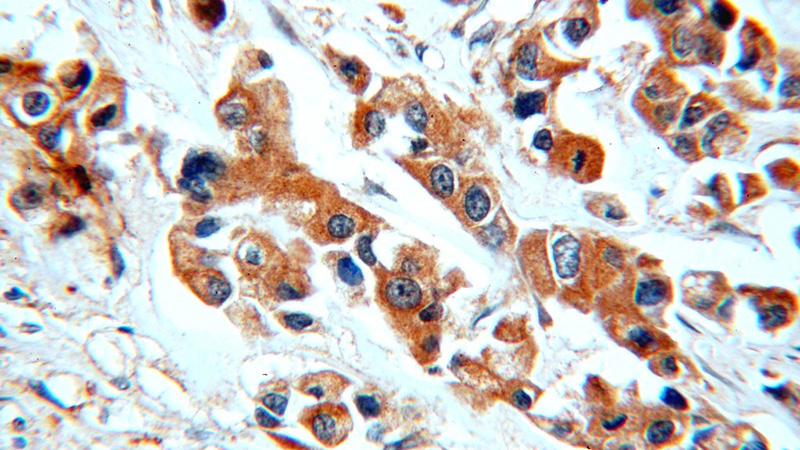
Immunohistochemical of paraffin-embedded human breast cancer using Catalog No:112125(KRT10 antibody) at dilution of 1:50 (under 40x lens)

-
Product Name
KRT10 antibody
- Documents
-
Description
KRT10 Rabbit Polyclonal antibody. Positive IHC detected in human breast cancer.
-
Tested applications
ELISA, IHC
-
Species reactivity
human, mouse, rat; other species not tested.
-
Alternative names
KRT10 antibody; Cytokeratin 10 antibody; KPP antibody; CK 10 antibody; CK10 antibody
-
Isotype
Rabbit IgG
-
Preparation
This antibody was obtained by immunization of KRT10 recombinant protein (Accession Number: NM_000421). Purification method: Antigen affinity purified.
-
Clonality
Polyclonal
-
Formulation
PBS with 0.1% sodium azide and 50% glycerol pH 7.3.
-
Storage instructions
Store at -20℃. DO NOT ALIQUOT
-
Applications
Recommended Dilution:
IHC: 1:20-1:200
-
Validations

Immunohistochemical of paraffin-embedded human breast cancer using Catalog No:112125(KRT10 antibody) at dilution of 1:50 (under 10x lens)
Immunohistochemical of paraffin-embedded human breast cancer using Catalog No:112125(KRT10 antibody) at dilution of 1:50 (under 40x lens)
-
Background
Keratins are a large family of proteins that form the intermediate filament cytoskeleton of epithelial cells, which are classified into two major sequence types. Type I keratins are a group of acidic intermediate filament proteins, including K9–K23, and the hair keratins Ha1–Ha8. Type II keratins are the basic or neutral courterparts to the acidic type I keratins, including K1–K8, and the hair keratins, Hb1–Hb6. As a type I keratin, keratin 10 is a suprabasal marker of differentiation in stratified squamous epithelia.
Related Products / Services
Please note: All products are "FOR RESEARCH USE ONLY AND ARE NOT INTENDED FOR DIAGNOSTIC OR THERAPEUTIC USE"
